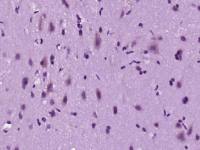
Sprouty 2快速发育生长因子同源蛋白2抗体

相关产品推荐更多 >
万千商家帮你免费找货
0 人在求购买到急需产品
- 详细信息
- 技术资料
- 供应商:
上海联迈生物工程有限公司
- 库存:
大量
- 靶点:
详见说明书
- 级别:
1
- 目录编号:
LM-13070R-FITC
- 克隆性:
多克隆
- 抗原来源:
Rabbit
- 保质期:
1年
- 抗体英文名:
Anti-ENOSF1/FITC
- 抗体名:
Anti-ENOSF1/FITC
- 标记物:
FITC标记
- 宿主:
Human, Dog, Rabbit,
- 适应物种:
Human, Dog, Rabbit,
- 免疫原:
详见说明书
- 亚型:
IGg
- 形态:
粉末、液体、冻干粉
- 应用范围:
ICC=1:50-200 IF=1:50-200
- 浓度:
1mg/ml
- 保存条件:
-20 °C
- 规格:
100ul
FITC标记的烯醇化酶超家族成员1抗体
| 英文名称 | Anti-ENOSF1/FITC |
| 中文名称 | FITC标记的烯醇化酶超家族成员1抗体 |
| 别 名 | Enolase superfamily member 1; ENOSF 1; HSRTSBETA; RTS alpha; RTS; RTS beta; RTS beta protein; TYMSAS; |
| 规格价格 | 100ul/2980元 购买 大包装/询价 |
| 说 明 书 | 100ul |
| 研究领域 | 肿瘤 细胞生物 信号转导 新陈代谢 |
| 抗体来源 | Rabbit |
| 克隆类型 | Polyclonal |
| 交叉反应 | Human, Dog, Rabbit, |
| 产品应用 | ICC=1:50-200 IF=1:50-200 not yet tested in other applications. optimal dilutions/concentrations should be determined by the end user. |
| 分 子 量 | 50kDa |
| 性 状 | Lyophilized or Liquid |
| 浓 度 | 1mg/ml |
| 免 疫 原 | KLH conjugated synthetic peptide derived from human ENOSF1 |
| 亚 型 | IgG |
| 纯化方法 | affinity purified by Protein A |
| 储 存 液 | 0.01M TBS(pH7.4) with 1% BSA, 0.03% Proclin300 and 50% Glycerol. |
| 保存条件 | Store at -20 °C for one year. Avoid repeated freeze/thaw cycles. The lyophilized antibody is stable at room temperature for at least one month and for greater than a year when kept at -20°C. When reconstituted in sterile pH 7.4 0.01M PBS or diluent of antibody the antibody is stable for at least two weeks at 2-4 °C. |
| 产品介绍 | background: The rTS gene codes for a naturally occurring antisense RNA to thymidylate synthase (TS) mRNA and two proteins (rTSalpha and rTSbeta (also known as ENOSF1)). The role of the major protein product of rTS, ENOSF1 has been linked to alterations in TS protein expression, but the precise function of ENOSF1 is unknown. Expression of rTS is associated with growth arrest in cell culture, but its overexpression has been noted in cells resistant to anticancer drugs such as 5-fluorouracil and methotrexate. Studies have shown that increased expression of ENOSF1 is associated with the decrease in TS protein expression due to production of novel, diffusible signal molecules. Function: May regulate thymidylate synthase activity. Subcellular Location: Mitochondrial. Post-translational modifications: Could be sumoylated. Similarity: Belongs to the mandelate racemase/muconate lactonizing enzyme family. ENOSF1 subfamily. Database links: UniProtKB/Swiss-Prot: Q7L5Y1.1 Important Note: This product as supplied is intended for research use only, not for use in human, therapeutic or diagnostic applications. |
风险提示:丁香通仅作为第三方平台,为商家信息发布提供平台空间。用户咨询产品时请注意保护个人信息及财产安全,合理判断,谨慎选购商品,商家和用户对交易行为负责。对于医疗器械类产品,请先查证核实企业经营资质和医疗器械产品注册证情况。
 技术资料
技术资料暂无技术资料 索取技术资料
FITC标记的烯醇化酶超家族成员1抗体
¥2980